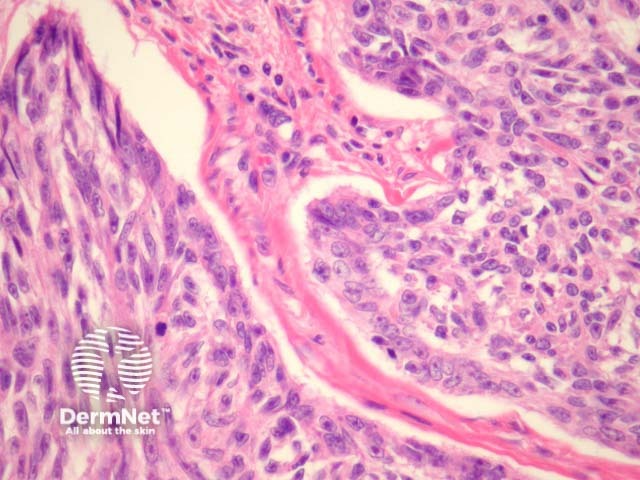
Figure 2

Main menu
Common skin conditions
NEWS
Join DermNet PRO
Read more
Quick links
Author: Assoc Prof Patrick Emanuel, Dermatopathologist, Auckland, New Zealand, 2013.
Erickson et al. were the first to report malignant basomelanocytic tumour, describing a tumour with an intimate admixture of malignant basaloid cells and malignant melanocytes. Some authors (myself included) believe these tumours are a collision between a basal cell carcinoma and malignant melanoma.
Low power examination of malignant basomelanocytic tumour show an infiltrating dermal tumour with features of a basal cell carcinoma replete with peripheral palisading and retraction around the tumour islands (figure 1). Higher power magnification may be needed to identify malignant melanocytes. Prominent nucleoli can be a helpful feature as these are not typically seen in regular basal cell carcinomas (figure 2).

Figure 1
Figure 2

Figure 3
Melan-A can be used to highlight the malignant melanocytes infiltrating the basaloid islands (figure 3). The background basaloid proliferation can be illustrated with stains for p63 or keratins.
The malignant melanoma could be overlooked as the scanning magnification architecture of the basal cell carcinoma is retained. The biphasic appearance of malignant basomelanocytic tumour may also mimic a basal cell carcinosarcoma. Immunohistochemical studies can prove useful in confirming the diagnosis.